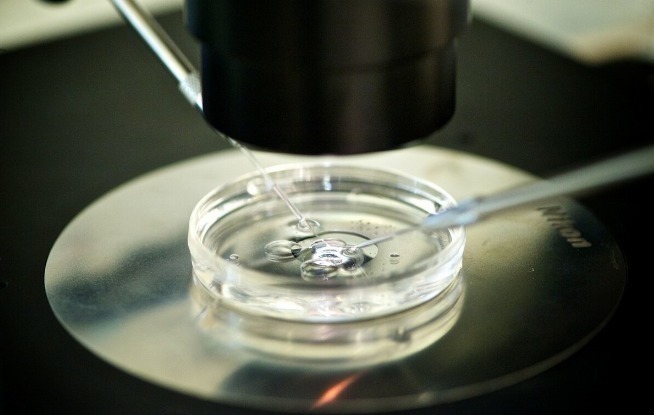
玻璃器皿|试管婴儿取卵会很痛取完之后是什么情况呢

玻璃器皿|试管婴儿取卵会很痛取完之后是什么情况呢
试管婴儿在目前是一项常见的生殖辅助受孕技术,在操作的过程中主要将女性身体的卵子取出在体外和精子结合,形成受精卵后再放到女性宫腔内着床发育。此项手术成功率较高,可以满足女性当母亲的愿望,但有些女性又担心试管婴儿在取卵时会痛苦,试管婴儿取卵的过程到底是怎么样的?【 玻璃器皿|试管婴儿取卵会很痛取完之后是什么情况呢】

文章插图
试管婴儿取卵会痛苦吗?一般来讲,在做取卵手术时所带来的疼痛是可以忍受的,其实这种疼痛和女性的疼痛忍耐值有关,也和她们的心理有关系。一些女性对疼痛的忍耐程度较低,在进行时就会感觉特别痛苦,但是不用过于担心,因为在取卵前大多数医生会采取一些止痛措施,如麻醉、口服止痛药等,会让女性根据自己对疼痛的忍受度而选择止痛方法来降低带来的疼痛。另外一般在取卵后大多数女性会有腹部疼痛坠胀感,这主要是因为在手术时灌入二氧化碳使盆腔有少量积液导致,不用过于担心。
文章插图
取卵手术的过程到底是怎么样的?在取卵前医生会对女性的阴道进行消毒和冲洗,而且会让女性排尿,膀胱处于排空状态。而在取卵时会用探针穿刺卵巢,再将B超探头放入阴道内,借助探头上的针管来吸取卵巢中的卵泡,在吸取成功后将卵泡放在试管内,将取出的卵泡放入玻璃器皿内并且在显微镜下选择出优质卵子取出,放在另外的器皿当中等待成熟。取卵后会有哪些情况?女性在取卵后阴道会有少量出血,不用过于紧张,主要是因为穿刺阴道导致,一般在两三天内就会消失,又或者通过B超探头下取卵会伤及血管导致出血现象,也不用过于焦虑,只要不会伴随着其他不适就不用担心。不过要注意,在取卵后如果有发烧、阴道大量出血、腹部疼痛并且其他不适症状需及时就医,在医生指导下进行检查采取措施,毕竟这些属于取卵后的副作用,如果拖延只会带来伤害。

文章插图
温馨提示,试管婴儿在目前很常见,大多数夫妻为了满足自己拥有宝宝的愿望而选择此项方法,而在操作的过程中取卵是一个必不可少的过程,因此女性对取卵过程可以做了解,并且对于取卵后会出现的症状有所掌握,才能在出现症状时不会惊慌失措。
- 第三代试管婴儿PGT筛查有哪些优点和缺点?
- 试管婴儿四代技术的前世今生!
- 妈妈|当年不听劝阻,执意做试管婴儿的“无腿妈妈”,生活现状让人动容
- 的结果|43岁咸素媛生产半年猴急怀二胎,做试管婴儿失败痛哭不止
- 做济南试管婴儿费用的高低有哪些因素影响?
- 做试管婴儿怀孕的朋友该如何计算预产期呢?
- 避免试管婴儿胚胎着床失败,这些因素是关键!
- 生育|还记得中国首位“试管婴儿”吗?如今她已33岁,活成了这个模样
- 移植|记得1988年国内第一例试管婴儿吗?经过很多转变后,如今这样
- 宝宝|“试管婴儿”长大后和正常宝宝有2点不同,试管医生说出了实情!